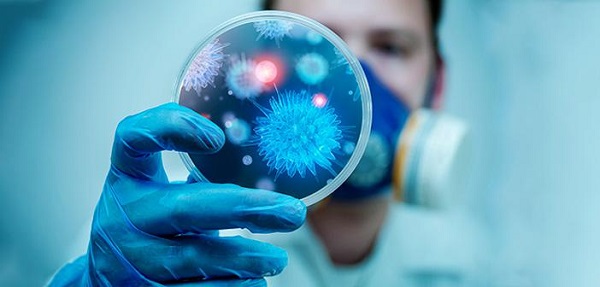
Kronik hastalar dikkat! Sakın geç kalmayın

Okulların açılmasıyla birlikte, kapalı alanlarda geçirilen süre arttı. Bu ise hastalıkların artmasına yol açtı.
Çocuk Sağlığı ve Hastalıkları Uzmanı Dr. Cansu Yılmaz, önemli açıklamalarda bulundu. Soğuk havaların giderek arttığı sonbahar mevsiminde çocukların daha sık hastalandığına dikkat çeken Medicana Bursa Hastanesi Çocuk Sağlığı ve Hastalıkları Uzmanı Dr. Cansu Yılmaz, "Çocuklarda sık görülen hastalıklar, akut solunum yolu enfeksiyonları, soğuk algınlığı, grip, orta kulak yolu enfeksiyonu, dış kulak yolu enfeksiyonu, sinüzit, farenjit, larenjit, bronşit, krup, zatüre, rotavirus ishalleri, el ayak ağız hastalığı, idrar yolu enfeksiyonlarıdır. Okullarda en sık görülen bulaşıcı hastalıklar, döküntülü çocukluk çağı hastalıkları, grip, nadiren de olsa menenjit, hepatit A (sarılık) ve paraziter enfeksiyonlardır. Okul çağında sık gördüğümüz enfeksiyonlardan korunmak için, tüm aşıları yaptırmak, el yıkamak, yeterli ve düzenli beslenmek, sıvı tüketmek, uyku saatlerine dikkat etmek, mevsime uygun kıyafetler giymek, düzenli spor yapmak gerekir. Özellikle aileler ve öğretmenler hijyene çok dikkat etmelidir" dedi.
Döküntülü çocuk çağı hastalıklarından kızamık, kızamıkçık, kabakulak, su çiçeği gibi hastalıklarda aşı ile korunmanın mümkün olduğunu ifade eden Yılmaz, "Bulaşıcı döküntülü çocukluk çağı hastalıkları geçiren çocuğun okula gönderilmemesi gerekir. En sık okul döneminde nezle, grip görülmekte ve öksürük, ateş, halsizlik ile seyreder. Grip aşısı 6. aydan itibaren yapılmaktadır. Dışkı ile kirlenmiş yiyeceklerin ağız yolu ile alınması sonrası hepatit A (sarılık) bulaşabilir. Aşılama ve gıdaların yıkanarak yenmesi ile korunmak mümkündür" şeklinde konuştu.